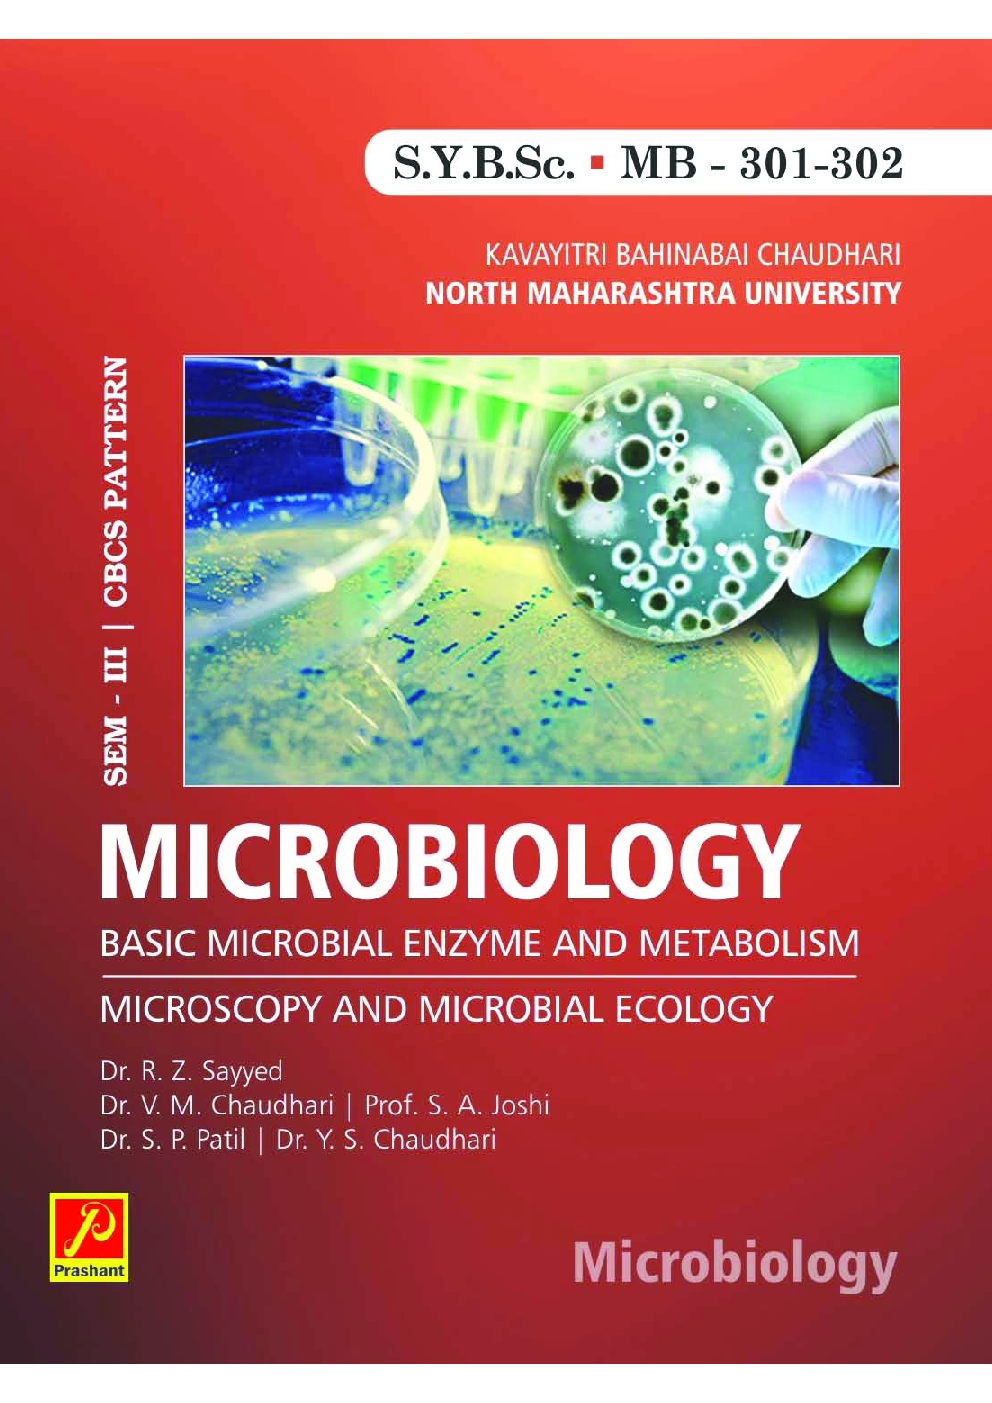
Microbiology - Page 1

Microbiology by Dr. R.Z. Sayyed, Dr. V.M. Chaudhari, Dr. S.A. Joshi, Dr. S.P. Patil, Dr Y. S. Chaudhari
Book Summary:
Microbiology involves the study of the fascinating world of unicellular microscopic organisms which includes both eukaryotic organisms such as fungi and protists, as well as prokaryotic organisms viz. bacteria, viruses, etc. While microorganisms are often viewed negatively due to their involvement in many diseases, they are also responsible for many beneficial processes such as industrial fermentation, antibiotic production and as the vehicles for cloning in higher organisms. They are also exploited to produce many commercially viable enzymes, proteins, vitamins, growth factors, etc. They benefit our environment in many ways such as their role in biodegradation or bioremediation of domestic, agricultural and industrial wastes.
Microbiology is a broad and multifaceted discipline that encompasses many specialized areas. The knowledge of microbiology has expanded a lot in recent years and this subject has been included in the syllabi of many universities at both undergraduate and postgraduate levels.
It gives a sense of satisfaction to the authors to bring out this textbook for Second Year B.Sc Choice Based Credit System syllabus as prescribed by Kavitri Bahinabai Chaudhari North Maharashtra University, Jalgaon as per the guidelines U.G.C. This book has two theory papers MB 301 – Basic Microbial Enzyme and Metabolism & MB 302- Microscopy and Microbial Ecology. Authors have made a sincere attempt to provide the students with a basic guideline for study and also gain knowledge of the subject. The book is merely an outcome of the compilation of microbiology literature and research done by various scientists in different areas of microbiology. The primary interest of the authors is to present the subject matter with simplicity and clarity, good examples added with good figures.
Audience of the Book :
This book Useful for B.Sc Student.
Table of Content:
Basic Microbial Enzyme And Metabolism
1. Microbial Enzymes
2. Nutrient Uptake And Transport
3. Microbial Metabolism
Microscopy And Microbial Ecology
1. Microscopy
2. Microbial Ecology
3. Microbial Interactions In Extreme Habitats